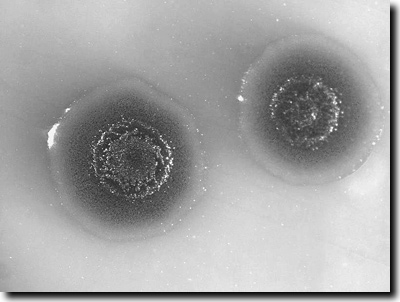

Synthetische Biologie – Leben zusammenbauen?
von Harald Binder
Studium Integrale Journal
17. Jahrgang / Heft 2 - November 2010
Seite 68 - 75
Zusammenfassung: Unter „Synthetischer Biologie“ werden verschiedene Methoden aus Molekularbiologie und Biotechnologie zusammengefasst und mit der Perspektive versehen, diese kreativ zu nutzen. Dabei sollen Prozesse und Mechanismen aus der Biosphäre aus ihrem natürlichen Zusammenhang herausgelöst und dazu eingesetzt werden, neue von Menschen definierte Frage- und Problemstellungen zu bearbeiten und zu lösen. Eine spektakuläre Zielvorstellung ist dabei die Herstellung von Systemen, die bestimmte Aspekte lebendiger Zellen erfüllen sollen. Autoren, die sich auf diesem Forschungsfeld betätigen, sprechen häufig auch ethische Herausforderungen an. Dabei ist noch gar nicht absehbar, ob tatsächlich neuartige ethische Probleme auftreten.
Allerdings scheinen mit den Versuchen, Leben technisch zu erzeugen, unsere etablierten Vorstellungen von Lebewesen und vom Leben selbst in Frage gestellt zu werden.
• • • • • • •
Einleitung
Die Verknüpfung der beiden Begriffe „Synthese“ und „Biologie“ ist uns bereits seit langem als „Biosynthese“ vertraut. Schon immer haben Menschen die Syntheseleistungen von Pflanzen, Mikroorganismen und Tieren – also ihre Fähigkeit, Substanzen durch Zusammenfügen chemischer Bausteine zu erzeugen – genutzt und davon profitiert, z. B. in Form von Nahrung oder Extrakten aus Pflanzenteilen als Heilmittel. Bis heute stellt die unüberschaubare Fülle an Syntheseprodukten aus der belebten Natur eine unerschöpfliche Inspirationsquelle für Naturstoffchemiker dar. Sie bauen diese Stoffe – nach ihrer Isolierung und Strukturanalyse – nach, modifizieren sie und gewinnen so Anregungen und Ideen, z. B. im Blick auf neue Medikamente. Die Syntheseleistungen der Biosphäre stellen also einen wesentlichen Teil der Lebensgrundlage für uns Menschen dar und darüber hinaus bieten sie einen reichen Fundus an herausfordernden Anregungen für Forschung und Entwicklung.
Die aktuelle und in den vergangenen Jahren populär gewordene umgekehrte Verknüpfung von „Synthese“ und „Biologie“ als „Synthetische Biologie“ deutet an, dass chemisch-technische Synthesemethoden genutzt werden sollen, um biologische Systeme kreativ, d. h. über deren natürlich vorkommendes Potential hinaus zu nutzen, z. B. für die Herstellung neuer Substanzen oder für erweiterte biochemische Abbaureaktionen. Darüber hinaus werden aber auch Projekte betrieben, in deren Verlauf lebende Systeme, wie z. B. rein chemisch synthetisierte Zellen oder solche mit minimalem Genom (Erbgut), hergestellt werden sollen. In diesem Beitrag werden aktuelle Arbeiten aus dem Bereich der Synthetischen Biologie vorgestellt und die zu Grunde liegenden Konzepte und deren ethische Konsequenzen kritisch reflektiert.
Ein Blick zurück
„Synthetische Biologie“ ist ein Begriff, der in den vergangenen Jahren zunehmend populär wurde durch häufige Verwendung auch in Zusammenhang mit spektakulären Erwartungen neuer Lebensformen aus dem Labor. Im Internet gibt es eine ursprünglich von Studenten (vom MIT und aus Harvard) initiierte offene Seite (OpenWetWare) zur Synthetischen Biologie, die derzeit von verschiedenen Einzelpersonen, aber auch von etablierten Labors und Arbeitsgruppen genutzt wird (http://syntheticbiology.org/). Im Jahr 2004 fand in Cambridge (Massachusetts, USA) die erste Tagung Synthetic Biology statt. Es folgten weitere Tagungen 2006 in Berkeley, 2007 in Zürich und 2008 in Hong Kong. Die nächste ist für 2011 in Stanford geplant. Daneben war „Synthetische Biologie“ Thema bei vielen weiteren, bereits etablierten wissenschaftlichen Konferenzen und Tagungen.
Der Begriff „Synthetische Biologie“ taucht in der Fachliteratur aber bereits viel früher auf. Die heutigen Bemühungen vorwegnehmend verwendet ihn der polnische Genetiker und Onkologe Szybalski. Er schrieb 1978 im Zusammenhang mit der Würdigung des Medizin-Nobelpreises für Werner Arber, Daniel Nathans und Hamilton O. Smith (Charakterisierung und Anwendung von Restriktionsenzymen), dass mit Restriktionsenzymen* ein neuer Bereich der Synthetischen Biologie zugänglich sei, in dem bestehende Gene nicht nur analysiert und beschrieben werden können, sondern auch neue Anordnungen von Genen entworfen und bewertet werden können1 (Szybalski 1978). Bereits 1912 hatte der französische Wissenschaftler Leduc eine Arbeit unter dem Titel „La Biologie Synthétique“ veröffentlicht. Darin skizzierte er seine Vorstellungen zur Synthese von Leben durch Anwendung „der physikalischen Kräfte, die es verursachen“, wobei für Leduc Osmose eine bedeutende Rolle spielte.
Glossar
In vitro: im (Reagenz-)Glas, zur Ab-grenzung von Vorgängen in lebenden Zellen, bzw. Organismen (in vivo). Lipidmembran: Lipide (= Fette) bilden ebenso wie alle Moleküle, die einen wasserabstoßenden (hydrophoben) und einen wasserlöslichen (hydrophilen) Bereich aufweisen, an Grenzflächen (z. B. Wasser/Luft) spon-tan flächig organisierte Schichtverbände aus. Am Aufbau von Biomembranen sind verschiedene Lipide und Proteine beteiligt. Nukleotide: Bausteine (Monomere) der Nukleinsäuren. Sie sind aus Kohlenhydraten, N-Heterocyclen und Phosphaten zusammengesetzt. Je nachdem, ob wenige oder viele Nu-kleotide miteinander verknüpft sind spricht man von Oligo- oder Polynukleotiden. Mononukleotide sind die Einzelbausteine: Adenin (A), Guanin (G), Cytosin (C), Tymin (T) und Uracil (U; in RNA anstelle von T). Pathogenität: Krankheitsauslösende Eigenschaft von (Mikro-) Organismen oder Stoffen. Restriktionsenzyme: spezifische biologische Katalysatoren (Enzyme), die DNA-Moleküle spalten können. Man unterscheidet verschiedene Ty-pen von Restriktionsenzymen (auch als Restriktionsnukleasen bezeichnet). Vesikel: Von Membranen umschlossene Bläschen.
Versuche einer Skizzierung


Abb. 1: Aufbau der DNS. Links Doppelhelix, Z = Zucker Desoxyribose, P Phosphatrest. Rechts die vier Grundbausteine (Basen) der DNS. Je zwei Basen passen genau zueinander und sind daher „komplementär“. Die Basenpaarung erfolgt über Wasserstoffbrücken (gepunktete Linien). Mittels der DNS-Sequenz (Abfolge) werden die Reihenfolgen der Aminosäuren in den Proteinen programmiert. Ein Triplett steht für eine Aminosäure. (Aus Junker & Scherer 2006)
Auf der Internetseite Synthetic Biology (s. o.) wird diese Disziplin in zwei Punkten beschrieben: A) Entwerfen und Konstruieren neuer biologischer Teile, Baugruppen und Systeme und B) Neukonstruktion existierender biologischer Systeme für nützliche Anwendungen. Benner & Sismour (2005) führen ebenfalls zwei umfassende Teilbereiche an: Zum einen den Einsatz unnatürlicher Moleküle, um biologische Phänomene nachzubilden und zum zweiten die Suche nach austauschbaren Teilen aus der natürlichen Biologie, um diese in Systeme einzufügen, so dass sie neue Funktionen ausführen, für die wir kein Vorbild aus der Natur kennen.
Bei „Synthetischer Biologie“ handelt es sich also nicht um ein völlig neu entworfenes Forschungsprogramm, sondern eher um ein Dach, unter dem verschiedene bereits etablierte Forschungsbereiche vereinigt werden und die gemeinsam völlig neue und attraktive Perspektiven eröffnen. Zu diesen genannten Bereichen gehören die Molekularbiologie, Gentechnik, Systembiologie, Biotechnologie u. a.
Für Benner & Sismour (2005) eröffnet die Synthetische Biologie Zugänge zu Erkenntnissen, die den komplementären Methoden von Beobachtung und Analyse nicht zugänglich sind.
Bei analytischem Vorgehen sehen sie die Gefahr, dass man in Datensätzen vermeintlich Muster und Regelhaftigkeit erkennt, wo gar keine vorhanden sind, und daraus Vorstellungen und Modelle ableitet, die zu keiner sinnvollen Erklärung führen und somit nicht fruchtbar gemacht werden können. Mit einem synthetischen Ansatz dagegen können hochgesteckte Ziele formuliert werden, wie z. B. einen Menschen auf den Mond zu bringen („put-a-man-to-the-moon“ goal), die man dann unter Nutzung aller verfügbaren Ressourcen mit großen Anstrengungen zu erreichen versucht. Dabei müssen viele verschiedene Aspekte berücksichtigt und auch vorher ungeahnte Probleme gelöst werden. Wenn man auch nur scheinbar unbedeutende Aspekte übersieht oder ausblendet, dann wird das Ziel nicht erreicht, die Mission misslingt. Die Autoren illustrieren das anhand eines Beispiels aus der Chemie, der Synthese von Vitamin B12. Der Nachbau dieses komplexen Naturstoffs gelang erst nach jahrelangen Bemühungen unter Beteiligung verschiedener Arbeitsgruppen (v. a. Woodward und Eschenmoser). Auf dem Weg zu diesem Ziel wurden bedeutende Zusammenhänge zum stereochemischen Verlauf chemischer Reaktionen aufgeklärt und das Verständnis für chemische Bindungen vertieft. Darüber hinaus wurden im Rahmen dieser Synthesebemühungen Anstöße zur Weiterentwicklung chromatographischer Methoden gegeben. Vergleichbar fruchtbare Auswirkungen erhoffen sich nun Benner & Sismour auch von der Synthetischen Biologie. Inwiefern der hier angeführte Vergleich zwischen Erfahrungen aus der chemischen Synthese und den Hoffnungen im Blick auf die Synthetische Biologie angemessen ist, soll in der abschließenden Diskussion reflektiert werden.
Beispiele

Abb. 2: Allgemeine Darstellung von PNA- und DNA-Strängen, unter Hervor-hebung der strukturellen Ähnlichkeit. B = Nucleobase.
Nukleinsäuren. Bereits vor der Publikation von Watson & Crick (1953) zur molekularen Struktur des Erbmoleküls DNA waren Hinweise auf den modularen Aufbau der Nukleinsäure bekannt: Desoxyribose, Phosphat, die N-Heterocyclen Adenin (A) und Guanin (G) (Purine) sowie Cytosin (C) und Thymin (T) (Pyrimidine); wobei A und T sowie G und C jeweils paarweise in denselben Mengen vorkommen, was dann in der spezifischen Basenpaarung über Wasserstoffbrücken am DNA-Modell der Doppelhelix bestätigt wurde (Abb. 1). Inzwischen wurde das natürliche Rückgrat der DNA (mit Phosphat verknüpfte Desoxyribose-Moleküle) synthetisch modifiziert. Engholm et al. (1992) präsentierten DNA-ähnliche Moleküle, deren Rückgrat stattdessen aus Peptiden besteht: Peptid-Nukleinsäure (PNA, Abb. 2). Damit waren große Hoffnungen für die Medizin verknüpft, die aber trotz anhaltender Forschungsarbeiten (Nielsen 2010) nicht im erwarteten Umfang erreicht werden konnten. Joyce et al. (1987) haben im Zusammenhang mit der RNA-Welt-Hypothese chemisch weniger komplexe Alternativen zur Ribose im Rückgrat von Nukleinsäuren wie z. B. Glycerinderivate vorgeschlagen und diskutiert.
Die Arbeitsgruppe von Benner hat weiterhin andere künstliche DNA-Moleküle synthetisiert, die andere Basen als die natürlichen (G, A, T, und C) verwenden. Trotzdem können diese mit der natürlichen DNA Wasserstoffbrücken eingehen und so in DNA-Doppelhelices (vgl. Abb. 1) als Basenpaar eingebaut werden (Sismour et al. 2004). Damit ist eine Erweiterung des genetischen Alphabets gelungen, deren Funktionsfähigkeit jüngst erfolgreich mit der Polymerase-Kettenreaktion* (PCR) demonstriert werden konnte (Yang et al. 2010). Bereits Watson und Crick (1953) hatten im Schlusssatz ihres kurzen Artikels angedeutet, dass die von ihnen vorgeschlagene spezifische Paarung unmittelbar einen möglichen Kopiermechanismus für das genetische Material nahe legt2. Auf der Basis dieses DNA-Modells wurden in den Folgejahren Vorstellungen über die Übersetzung der genetischen Information in Proteine (Translation) entwickelt und experimentell im Labor erforscht. Matthaei, Nirenberg und Khorona entschlüsselten in den frühen 1960er Jahren den genetischen Code. Danach werden die 20 am Aufbau von Proteinen beteiligten Aminosäuren durch 43 = 64 mögliche 3-er Folgen (Tripletts) der 4 DNA-Basen (A, C, G und T) in der DNA-Sequenz codiert.
Die Entdeckung, dass eines der STOP-Codons UAG3, das die Übersetzung (Translation) der RNA-Sequenz in Proteine normalerweise beendet, unter besonderen Umständen aber auch für seltene Aminosäuren, Selenocystein und Pyrrolysin codieren kann, eröffnete Möglichkeiten zur Erweiterung des genetischen Codes. Denn diese Beobachtung war Ausgangspunkt zur Nutzung dieses Codons für weitere, nicht natürliche Aminosäuren. Vor allem in der Arbeitsgruppe von Peter G. Schultz wurden in den vergangenen Jahren (Wang et al. 2006) eine Vielzahl unnatürlicher Aminosäuren (ca. 70; Chang et al. 2010) von E. coli, Hefe und Säugerzellen in Proteine eingebaut. Um das zu bewerkstelligen, müssen jeweils neue Enzymsysteme hergestellt werden, die die entsprechenden Aminosäuren an die RNA-Moleküle (tRNA) binden, welche im Ribosom anhand der RNA-Sequenz die entsprechenden Aminosäuren für den Aufbau der Proteine anliefern (Abb. 3 ).
Abb. 3: Vom Gen zum Protein. A Die Erbinformation wird in der Sequenz der DNA-Basen A,T,C und G gespeichert und vererbt (vgl. Abb. 1). Wasserstoffbrückenbindungen sorgen dabei stets für korrekte Basenpaarung. B Ein komplizierter Enzymkomplex (RNA-Polymerase) stellt eine Arbeitskopie des Gens her, welche als messenger-RNA (mRNA) bezeichnet wird (in RNA wird Uracil statt Thymin verwendet). C Eine noch weit kompliziertere molekulare Maschine (Ribosom) ermöglicht, dass aminosäuretragende Transfer-RNS-Moleküle an die Basentripletts der mRNS angelagert werden. D Diese Aminosäuren werden am Ribosom zu einer wachsenden Kette verbunden. E Die Aminosäurekette faltet sich, meist unter Mitwirkung von Hilfsproteinen, zum funktionalen Protein zusammen. (Zeichnung nicht maß-stabsgetreu; aus Junker & Scherer 2006)
Grundsätzlich würde auch eine Veränderung des genetischen Codes von Tripletts (mit 64 Variationsmöglichkeiten) in Quadrupletts (mit 44 = 256 möglichen 4-er Folgen) den Variationsspielraum erheblich erweitern. Neumann et al. (2010) ist auf dem Weg dahin ein entscheidender Schritt gelungen. Sie konnten das aktive Zentrum des Ribosoms derart verändern, dass vier anstelle von normalerweise drei Nukleotiden als eine kodierende Einheit erkannt werden. Damit dieses modifizierte Ribosom aber genutzt werden kann, müssen auch die tRNAs verändert werden, denn diese lesen die Boten-RNA (mRNA) mit der genetischen Information durch ihre entsprechenden Anticodons ab und liefern so die entsprechenden Aminosäuren an (vgl. Abb. 3). Auch neue Synthasen (Enzyme, die die tRNAs mit den entsprechenden Aminosäuren beladen) haben Neumann und Mitarbeiter hergestellt. Mit der Demonstration, dass dieses System funktioniert, ist ein Tor aufgestoßen, das ein weites Feld zur kreativen Nutzung künstlicher genetischer Codes eröffnet (Chen & Schindlinger 2010). In biologischen Systemen können Proteine nahezu beliebig modifiziert werden durch Einfügen von Bausteinen mit speziellen Funktionen oder deren physikalisch-chemische Eigenschaften verschiedenen Anforderungen angepasst werden.
Genome (Erbgut). Die heutige enorme Leistungsfähigkeit der Analyse von Nukleinsäuresequenzen und die dadurch erzeugten Datenmengen über die Erbinformationen verschiedenster Lebewesen stellen neue Ausgangspunkte zu Schritten in die umgekehrte Richtung dar: Man möchte ganze Genome neu synthetisieren. 2002 berichteten Wimmer und seine Mitarbeiter über die rein chemische Synthese der DNA eines Poliovirus mit einem Umfang von ca. 7.500 Basenpaaren (bp; Cello et al. 2002). Die Autoren konnten zeigen, dass man allein auf Basis der Sequenzdaten eines Genoms dieses im Labor unter Anwendung chemischer Methoden herstellen kann, um dann in Wirtszellen damit infektiöse Viruspartikel herzustellen. Eine Methode, die es erlaubt, das Genom von Bakterien-Viren (Phage ΦX174) mit 5.386 bp synthetisch innerhalb von 14 Tagen herzustellen, beschrieb die Arbeitsgruppe um Venter im Jahr 2003 (Smith et al. 2003). Ebenfalls in den Labors von Craig Venter gelang 2008 die Synthese des kompletten Genoms von Mycoplasma genitalium mit 582.970 bp, rund 100-mal länger als die Viren-Genome. Das synthetische Mycoplasma-Genom wurde anschließend auch in Mycoplasma-Zellen eingeschleust, deren natürliches Genom man zuvor entfernt hatte. Jüngst wurde die Herstellung eines weiteren, noch umfangreicheren Mycoplasma-Genoms (Mycoplasma mycoides, Abb. 4) mit über 1 Million bp vom selben Autorenteam veröffentlicht (Gibson 2010). Damit ist eindrucksvoll die derzeitige Leistungsfähigkeit von Labormethoden demonstriert, die die Synthese mindestens kleiner bakterieller Genome ermöglichen. Dabei wurden in allen genannten Beispielen aber natürlich vorkommende Genome (höchstens mit kleineren unbedeutenden Variationen) nachgebaut; die Synthesen der künstlichen Genome orientierte sich bisher ohne Ausnahmen sehr eng an den natürlichen Vorbildern.
In allen Fällen wurden natürlich vorkommende Genome nachgebaut.
In der Natur finden wir eine auffällige Vielfalt der Genome von Lebewesen, die zu einer Population (und damit zu selben Art) gehören; (fast) kein Genom gleicht dem anderen. Diese Vielfalt ist die Voraussetzung, dass sich Populationen an veränderliche Lebensumstände anpassen können. Die etablierten Methoden zur künstlichen Erzeugung von genetischen Varianten im Labor sind aufwändig und zielen bisher nur auf die Veränderung einzelner Gene; sie sind deshalb wenig geeignet, gleichzeitige oder fortlaufende Veränderungen in Gen-Netzwerken ganzer Genome auszuführen. Church und Mitarbeiter haben kürzlich eine automatisierte Methode vorgestellt (Wang et al. 2009), die es erlaubt, in großem Stil gleichzeitig viele verschiedene Stellen eines Chromosoms in einer Zelle oder einer Population von Zellen gezielt zu verändern. Der zyklisch konzipierte Prozess ermöglicht somit die Erzeugung einer großen genetischen Vielfalt durch verschiedenste genetische Veränderungen wie Fehlpaarungen, Insertionen (Einfügungen) und Deletionen (Verluste). An einem Prototyp haben die Autoren die Leistungsfähigkeit des von ihnen entwickelten Systems demonstriert. In E. coli-Bakterien optimierten sie die Biosynthese eines bestimmten Kohlenhydrats (1-Deoxy-D-xylose-5-phosphat), das für die verbesserte Produktion von Lycopin, dem roten Tomatenfarbstoff4, notwendig ist. Im Demonstrationsexperiment wurden durch Einsatz von synthetischen DNA-Fragmenten gleichzeitig 24 Veränderungen im entsprechenden Kohlenhydrat-Stoffwechsel vorgenommen. Dabei wurden pro Tag 4,3 Milliarden Genvarianten erzeugt. Innerhalb von nur drei Tagen konnten E. coli-Varianten isoliert werden, deren Lycopin-Produktion um das Fünffache gesteigert war. Mit dieser Arbeit wurde eindrucksvoll demonstriert, dass heutzutage Methoden verfügbar sind, die Genome gleichzeitig an verschiedenen Positionen variieren, um bestimmte Eigenschaften zu generieren. Durch sehr effektive Erzeugung genetischer Varianten konnte ein ausgewählter Biosyntheseweg optimiert werden.
Abb. 4: Bakterienkolonien (Mycoplasma mycoides), denen ein modifiziertes Genom anderer Mycoplasma-Bakterien transplantiert wurde. Foto: J.Craig Venter Institute.
Zellen – Modelle, Minimalzellen. Ein weiterer Fokus der Synthetischen Biologie ist neben den komplexen molekularen Systemen die Zelle als kleinste lebendige Einheit.
Im Zuge der rasant wachsenden Zahl bekannter Genomsequenzen tauchte die Frage auf: Wie viele Gene benötigt eine Zelle als Minimalausstattung? Oder anders gefragt: Welche Gene reichen für die elementaren Erscheinungen des „Lebendigseins“ aus?
Basierend auf den Genomdaten für das Bakterium Mycoplasma genitalium (Fraser et al. 1995) initiierten die Autoren bereits damals eine Diskussion über ein minimales Genom. M. genitalium hatte das kleinste damals bekannte Genom und ist lebensfähig mit nur 524 Genen, wenn auch nur als Parasit. Foster & Church (2006) skizzierten daraufhin ein minimales Genom mit 151 Genen, wovon 38 für RNAs und 113 für Proteine kodierten. Dies sollte dann als minimale Zelle zusammengebaut werden, wobei die anvisierte Minimalzelle vor allem die Fähigkeit zur Reproduktion aufweisen sollte. Ihre Strategie sieht vor, zunächst biochemisch alleinstehende Module aus Teilsystemen zu etablieren, die sie anschließend Schritt für Schritt zu einer Minimalzelle integrieren wollen. Die Autoren listen die noch zu lösenden Probleme auf und äußern offen, dass die Herstellung von „Minimalzellen“ innerhalb des kommenden Jahrzehnts nur dann erfolgreich sein kann, wenn alle in den jeweiligen Bereichen führenden Labors auf der ganzen Welt kooperativ zusammenarbeiten. Foster & Church (2006) versprechen sich von Minimalzellen nicht nur einfache Testsysteme, sondern auch viele Anwendungen in der Biochemie im Sinne der „Synthetischen Biologie“.
Auch im Arbeitskreis um Craig Venter wurde ausgehend von Mycoplasma genitalium ein minimales Genom abgeleitet (Glass et al. 2006). M. genitalium ist der Organismus mit dem kleinsten bekannten Genom, der im Labor rein kultiviert werden kann. Experimentell wurden einzelne Gene zerstört und geprüft, ob der Organismus ohne ihre Funktion noch existenzfähig ist. Die Autoren leiten von ihren Beobachtungen ein Minimalgenom von 382 (der 485 in M. genitalium vorhandenen) proteincodierenden Genen plus 43 RNA-codierenden Genen ab. Die Diskussion über Inhalt und Umfang eines Minimalgenoms wird wohl offen bleiben, bis anhand eines künstlichen Minimalgenoms – integriert in ein zellähnliches System – dessen Funktionsfähigkeit (Reproduktion) unter Beweis gestellt werden kann. Dazu kommt, dass jede theoretische Diskussion über Minimalgenome immer auch von den Forderungen an ein minimales System abhängt, z. B.: Welche Nährstoffe werden zur Verfügung gestellt, was muss der Organismus selbst herstellen? Bisher ist ein solches System nicht konstruiert, charakterisiert und dokumentiert worden.
Einen anderen Weg der Synthetischen Biologie schlagen Jack Szostak und seine Mitarbeiter ein. Sie verwenden künstlich aufgebaute Modellzellen (Vesikel), in die biochemische Reaktionen – wie sie in Zellen ablaufen – eingeschlossen werden. Mansy et al. (2008) untersuchten z. B. die Durchlässigkeit von einfachen Lipidmembranen* im Blick auf die Synthese von Oligonukleotiden* in solchen Vesikeln*. Sie konnten sowohl die Diffusion von Mononukleotiden* durch die Membran in das Innere der Vesikel nachweisen als auch, dass die daraus im Vesikel synthetisierten Oligomere* in deren Innenraum verbleiben und das Vesikel nicht mehr verlassen. Untersuchungen dieser Art werden als Unterstützung für die Vorstellungen herangezogen, dass Zellmembranen auch sehr viel einfacher sein könnten als die Biomembranen, die heutige Zellen umhüllen. Jüngst hat Szostak seine Vorstellungen über solch vergleichsweise einfache Zellen und den möglichen Ursprung von lebenden Zellen in einem Übersichtsartikel zusammengefasst (Schrum et al. 2010). Die Autoren präsentieren Vesikel, deren einfache Membranen aus Fettsäuremolekülen aufgebaut sind, und untersuchen deren Dynamik (Wachstum und Aufspaltung in eine neue Generation kleiner Vesikel), sowie deren Kooperation mit modifizierten Nukleinsäurepolymeren. Sie betrachten das vorgestellte Labormodell als ein System, an dem Wege zur Entstehung des Lebens getestet werden können. Weitere ähnliche Untersuchungen zu minimalen Zellen stammen aus dem Labor von Luisi. Souza et al. (2009) stellen Untersuchungen zur Größe von minimalen künstlichen Zellen und deren Einfluss auf die darin eingeschlossenen Komponenten vor.
Die hier angeführten Modellzellen mit einfachen Membranen sind einerseits durchaus nützlich, um ausgewählte Eigenschaften zu simulieren und zu untersuchen. Die einfachsten biologischen Zellmembranen weisen jedoch sehr viel komplexere Zusammensetzungen auf, und es ist derzeit nicht absehbar, ob es gelingt, die Diskrepanz zu überbrücken und einen Weg von einfachen Modellmembranen hin zu komplexen Biomembranen plausibel zu machen.
Zellen mit synthetischem Genom
Einer der jüngsten und spektakulärsten Beiträge zur Synthetischen Biologie stammt aus dem Umfeld von Craig Venter. Das von ihm und seinen Mitarbeitern sequenzierte und mit Hilfe von Mutagenese-Studien analysierte Genom von Mycoplasma genitalium (Hutchinson et al. 1999) sollte zunächst synthetisch nachgebaut werden. Gibson et al. (2008) stellten ein M. genitalium-Genom mit 582.970 bp her. Darin waren alle Gene des Wildtyps enthalten, mit Ausnahme des für die Pathogenität* verantwortlichen Gens. Dieses war durch Einbau eines Antibiotika-Resistenzgens unterbrochen und damit funktionsunfähig gemacht worden. Der Anti-biotika-Marker diente dann der Selektion des synthetischen Genoms. Außerdem war zur Identifikation eine Art „Wasserzeichen“ an geeigneten Stellen im Genom eingefügt worden. Zuerst wurden Teilstücke mit einer Länge von 5000 bis 7000 bp aus chemisch synthetisierten Oligonukleotiden zusammen-gebaut. Durch Rekombination wurden aus diesen Teilstücken mit überlappenden Se-quenzbereichen an den Enden Genomteile aus 24 kb, 72 kb und schließlich 144 kb in vitro* erzeugt. Diese Polynukleotide wurden als künstliche Bakterienchromosomen in E. coli kloniert und korrekte Genomteile mittels Sequenzierung identifiziert. Das gesamte Genom kann aufgrund seiner Größe allerdings nicht mehr in Bakterien als künstliches Chromosom gehandhabt werden. Daher musste zu dessen Herstellung das System gewechselt werden. Das endgültige M. geni-talium-Genom wurde in Hefezellen (Saccharomyces cerevisiae) zusammengebaut. So ist die künstliche Herstellung dieses Genoms unter Nutzung etablierter biotechnologischer Methoden sowie durch Entwicklung neuer Technologien erst nach Überwindung zahlreicher Schwierigkeiten möglich geworden. Gleichzeitig musste parallel zu den Aufbauarbeiten jeder Schritt durch umfangreiche Sequenzierungen begleitet werden, um die korrekte Nukleotidabfolge im jeweiligen Genombereich sicherzustellen. Trotz aller Vorsichtsmaßnahmen musste schließlich festgestellt werden, dass bei der Zusammenfügung eines künstlichen Bakterienchromosoms ein Gen zerstört worden war, so dass das erzeugte Genom nicht für eine Überführung (Transplantation) in eine Empfängerzelle geeignet war. Die gewonnenen Erfahrungen und die entwickelten Technologien wurden dann in einem weiteren Projekt genutzt. Aufgrund limitierender Eigenschaften von M. genitalium bei der Kultivierung (z. B. geringe Wachstumsraten) wechselten Venter und sein Team auf andere, schneller wachsende Mycoplasma-Arten. My-coplasma mycoides (Abb. 4) wurde als Genom-Spender und M. capricolum als Genom-Empfänger gewählt (Lartigue 2007; 2009).
Ein modifiziertes Genom von M. myco-ides mit 1,08 Millionen bp und mit „Wasserzeichen“ (bestimmte Nukleotidabfolgen zur Identifikation des beabsichtigten Gentransfers) wurde in mehreren Durchgängen aus synthetischen Oligonukleotiden in Bakterien (E. coli) und in modifizierten Hefezellen (S. cerevisiae) zusammengebaut. Nach jeder Runde, in der Genfragmente zu größeren Einheiten zusammengebaut werden, musste der Erfolg überprüft und nachgewiesen werden (Gelelektrophorese, Sequen-zierung), damit die fehlerhaften Konstrukte aussortiert werden konnten. Nach der letzten Runde von sechs Durchgängen des Zusammenfügens konnte in einer von 48 Kolonien der vollständige Nachbau des M. mycoides-Genoms nachgewiesen werden (Gibson et al. 2010). Das so erzeugte Genom wurde dann in Zellen von M. capricolum transplantiert. Auch bei der Transplantation war eine Reihe von Problemen zu lösen. So erkennt die Empfängerzelle (Bakterienzelle) das Genom, das ja zuletzt in Hefezellen (einem Eukaryoten) zusammengebaut worden war, als fremdes Erbgut und baut dieses durch entsprechende enzymatische Reaktionen (Hydrolysen) ab. Diese Abbaureaktionen können aber dadurch verhindert werden, dass man die Enzyme in der Empfängerzelle ausschaltet oder das neue Genom teilweise mit Methylgruppen modifiziert.
Die Empfängerzellen (M. capricolum) mit dem synthetischen Genom zeigten dann tatsächlich die Erscheinungsform (Phänotyp) des Spenders M. mycoides, dessen Ge-nom nun die Zellen prägte. In der Laborkultur teilen und vermehren sich die neuen Zellen. In der zuletzt genannten Arbeit wird eindrucksvoll die derzeitige Leistungsfähigkeit der Biotechnologie demonstriert. Mit großem logistischen und technologischen Aufwand ist es gelungen, ein Bakteriengenom nachzubauen und seine Funktion in einer Zelle nachzuweisen. Dabei ist nicht Leben erzeugt worden, sondern man hat in Bakterienzellen das Erbgut ausgetauscht, welches man unter Nutzung biologischer – also lebender Systeme – hergestellt hat. Also hat man ein natürliches Genom (mit Modifikationen) nachgebaut. Wenn die Autoren die erzeugten Zellen als „synthetisch“ bezeichnen, ist das irreführend, denn die biochemische Grundausstattung bringt die Empfängerzelle mit, und auch das Genom ist zwar teilweise durch chemische Synthese hergestellt, aber in den wesentlichen Aspekten dem natürlichen Vorbild eines dem Empfängerorganismus sehr ähnlichen Bakteriums nachempfunden. Diese Bemerkungen sollen nicht die herausragenden logistischen und technischen Leistungen des Forschungsteams um C. Venter schmälern, sondern einen nüchternen Blick auf das Erreichte und die Grenzen des derzeit Möglichen anmahnen.
Versuch einer vorläufigen Einschätzung
Die Bedeutung des Forschungsfeldes, das unter dem Begriff „Synthetische Biologie“ zusammengefasst wird, kann u. a. auch daran gemessen werden, dass zu diesem Thema im Februar 2009 ein international besetzter Workshop unter der gemeinsamen Verantwortung der Deutschen Forschungsgemeinschaft (DFG), der Deutschen Akademie der Technikwissenschaften (acatech) und der Nationalen Akademie der Wissenschaften (Leopoldina) durchgeführt wurde. In dessen Folge wurde eine Stellungnahme publiziert (Synthetische Biologie Stellungnahme 2009). In diesem Dokument führen die Autoren ausgewählte Forschungs-felder auf: Chemische Synthesen von Genen und Genomen, Entwicklung von Minimalzellen (Zellen reduziert auf essentielle Lebensfunktionen), Generierung von Protozellen (künstliche Systeme mit Eigenschaften lebender Zellen), Design von maßgeschneiderten Stoffwechselwegen, Konstruktion von komplexen genetischen „Schaltkreisen“ und die Schaffung von neuartigen (orthogonalen) Biosystemen (modifizierte maschinenartige Zellkomponenten werden z. B. zur Produktion neuartiger Biopolymere genutzt).
In dem Papier werden auch ökonomische und ethische Fragestellungen angesprochen und diskutiert. Die Autoren der Studie erwarten zunächst einen wesentlichen Erkenntnisgewinn in der Grund-lagenforschung. Das Marktpotenzial der Synthetischen Biologie wird hoch eingeschätzt, obwohl derzeit überwiegend Grundlagenforschung betrieben wird. Als Anwendungsbereich wird v. a. die Pharmazie genannt: Medikamente, Nukleinsäure-Impfstoffe (Vakzine), neue Verfahren zur Gentherapie, aber auch umwelt- und ressourcenschonende Chemikalien-Herstellung.
Im Hinblick auf Aspekte der Sicherheit und des möglichen Missbrauchs wird in der Stellungnahme davon ausgegangen, dass gegenwärtig die Gesetze in Deutschland ausreichend sind. Angesichts der möglichen Entwicklungen werden einige formale Maßnahmen empfohlen. Die Autoren sprechen sich in Fragen der ethischen Beurteilung für baldigen öffentlichen Dialog aus.
Bei den Versuchen ist nicht Leben
erzeugt worden, sondern in Bakterien-
zellen wurde das Erbgut ausgetauscht, welches man unter Nutzung lebender
Systeme hergestellt hat.
Die Erfahrungen aus der Entwicklung und Anwendung der Gentechnik sollten uns gerade in diesem Bereich sensibilisieren. Die Bevölkerung – und alle werden von den hier angesprochenen Entwicklungen betroffen sein – sollte frühzeitig und differenziert über Entwicklungen und deren absehbare Folgen in vertrauenswürdiger und verständlicher Form informiert werden. Dies ist im Zusammenhang mit der Anwendung der Gentechnik in der Nahrungsmittelproduktion nur sehr eingeschränkt geschehen; mit weitreichenden negativen Folgen für das Vertrauen zwischen Verbrauchern auf der einen und Forschung, Anwendung und Nutzung auf der anderen Seite. Darüber hinaus hat dieses Versäumnis auch einen nur schwer einzuschätzen-den wirtschaftlichen Schaden verursacht, durch eine oft pauschale ablehnende Haltung gegenüber jeder Anwendung von Gentechnik in der Herstellung von Nahrungsmitteln.
Ein bedeutsames Detail beim Bemühen um einen vertrauensvollen und differenzierten öffentlichen Dialog ist auch die Verwendung klarer Be-griffe. Dies muss hier vor allem im Zusammenhang mit dem zuletzt aufgeführten Beispiel der Zellen mit synthetischem Genom betont werden. Wenn in Tagesmedien von der Herstellung „ersten synthetischen Lebens“ die Rede ist (z. B. Deutschlandradio vom 21.5.2010), dann ist hier differenzierte und verständliche Kommunikation nicht gelungen.
Eingangs wurde auf den Begriff der Synthese in der Chemie hingewiesen und darauf, dass die Synthese dort schon sehr lange einen fruchtbaren Beitrag zur Gewinnung neuer Erkenntnisse leistet. Die Methoden scheinen den Fragestellungen und Problemen angemessen zu sein. Nun wurden bereits in der Vergangenheit erfolgreich Methoden, die in einem Teilbereich der Naturwissenschaften fruchtbar waren, in die Biowissenschaften übertragen, z. B. in größerem Stil ab der Mitte des 20. Jahrhunderts aus der Physik. Dies hatte zur Folge, dass Fragestellungen aus neuen Blickwinkeln spezifischer formuliert und damit auch bearbeitet werden konnten. Als Beispiel sei die Vorlesung des theoretischen Physikers Erwin Schrödinger 1943 in Dublin unter dem Titel: „Was ist Leben?“ (Publikation 1944) genannt. Mit diesem Schritt wurde aber auch einer reduktiven Betrachtungsweise des Phänomens Leben Vorschub geleistet. Ein vergleichbarer Effekt ist auch von den Bemühungen im Bereich der Synthetischen Biologie zu erwarten und zwar umso mehr, je spektakulärer und technisch erfolgreicher deren Ergebnisse sind. Synthese als wesent-licher Ansatz zur Gewinnung von Erkenntnissen im Zusammenhang mit Leben ist letztlich nur dann wirklich angemessen, wenn dieses Phänomen auf seine materiellen Komponenten reduzierbar ist. Ob dies aber der Fall ist, kann bisher nicht positiv be-antwortet und mit guten Gründen in Frage gestellt werden.
Unter den wissenschaftlichen Kommentatoren der jüngsten spektakulären Ergebnisse der Synthetischen Biologie äußern manche auch durchaus Skepsis bezüglich der technischen Nutzbarkeit der Methoden. Ob die entwickelten Technologien im Blick auf bereits bekannte Verfahren konkurrenzfähig oder diesen gar überlegen sind, muss sich zukünftig erweisen (Bornscheuer 2010).
Bei aller gespannten Erwartung auf bedeutsame Erkenntnisse aus der Synthetischen Biologie sollten wir uns darum bemühen, die Wahrnehmung, unseren Umgang mit und die Wertschätzung von Leben nicht auf materielle Aspekte – auch nicht auf die synthetischen – zu reduzieren.
1 The work of restriction nucleases not only permits us easily to construct recombinant DNA molecules and to analyse individual genes, but also has led us into the new area of synthetic biology where not only existing genes are described and analysed but also new gene arrangements can be constructed and evaluated.
2 It has not escaped our notice that the specific pairing we have postulated immediately suggests a possible copying mechanism for the genetic material. (Watson & Crick 1953)
3 Dieses wird nach seinem Entdecker H. Bernstein auch als Amber Codon bezeichnet.
4 Lycopin ist unter der Bezeichnung E 160d als Lebensmittelfarbstoff in der EU zugelassen.
(2005) Synthetic Biology. Nature Rev. 6, 533-543.
Die erste künstliche Zelle – ein revolutionärer Schritt für die synthetische Biologie? Angew. Chem. 122, 5357-5359.
Chemical synthesis of Poliovirus cDNA: generation of infectious virus in the absence of natural emplate. Science 297, 1016-1018.
Adding new chemistries to the genetic code. Ann. Rev. Biochem. 79, 413-444.
Quadruplet codons: one small step for the ribosome, one giant leap for proteins. BioEssays 32, 650-654.
Peptide nucleic acids (PNA). Oligonucleotide analogues with an achiral peptide backbone. J. Am. Chem. Soc. 114, 1895-1897.
The minimal gene complement of Mycoplasma genitalium. Science 270, 397-403.
Towards synthesis of a minimal cell. Mol. Syst. Biol. doi:10.1038/msb4100090
Complete chemical synthesis, assembly and cloning of Mycoplasma genitalium genome. Science 319, 1215-1220.
Creation of a bacterial cell controlled by a chemically synthesized genome. Science 329, 52-56.
Essential genes of a minimal bacterium. Proc. Natl. Acad. Sci. USA 102, 435-430.
Global transposon mutagenesis and a minimal Mycoplasma genome. Science 286, 2165-2169.
The case for an ancestral genetic system involving simple analogues of the nucleotides. Proc. Natl. Acad. Sci USA 84, 4398-4402.
Genome transplantation in Bacteria: changing one species to another. Science 317, 632-638.
Creating bacterial strains from genomes that have been cloned and engineered in yeast. Science 325, 1693-1696.
Template-directed synthesis of a genetic polymer in a model protocell. Nature 454, 122-126.
Encoding multiple unnatural amino acids via evolution of a quadruplet-decoding ribosome. Nature 464, 441-444.
Peptide nucleic acids (PNA) in chemical biology and drug discovery. Chem. Biodivers. 7, 786-804.
‘Synthetic Biology’ makes its debut. Chem. Eng. News (24.3.2000), 49-53.
PCR amplification of DNA containing non-standard base pairs by variants of reverse transcriptase from Human Immunodeficiency Virus-1. Nucleic Acids Res. 32, 728-735.
The origins of cellular life. Cold Spring Harbor Perspektives Biol. doi: 10.1101/cshperspect.a002212.
Generating a synthetic genome by whole genome assembly: FX174 bacteriophage from synthetic oligonucleotides. Proc. Natl. Acad. Sci. USA 100, 15440-15445.
The minimal size of liposome-based model cells brings about a remarkably enhanced intrapment and protein synthesis. ChemBioChem 10, 1056-1063.
Microbial production of fatty-acid-derived fuels and chemicals from plant biomass. Nature 463, 559-562.
Nobel prizes and restriction enzymes. Gene 4, 181-182.
Expanding the genetic code. Ann. Rev. Biophys. Biomol. Struct. 35, 225-249.
Programming cells by multiplex genome engineering and accelerated evolution. Nature 460, 895-898.
Molecular structure of nucleic acids. A structure for desoxyribose nucleic acid. Nature 171, 737-738.
A chemical toolkit for proteins – an expanded genetic code. Nature Rev. Mol. Call Biol. 7, 775-782.
Expanded genetic alphabets in the polymerase chain reaction. Angew. Chem. 122, 181-184.
Letzte Änderung: 19.11.2010 •